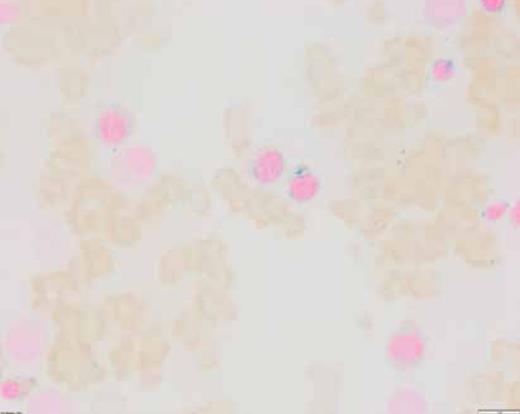
Iron stain performed on the bone marrow aspirate smear. Ring sideroblast counts are increased.
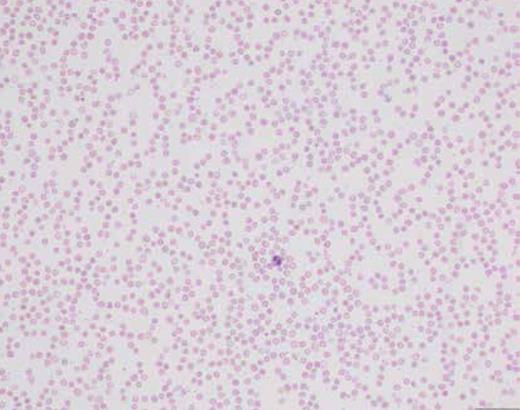
Peripheral blood smear. The figure shows marked anemia and neutropenia with adequate platelets.

Editor’s Note: With this issue of The Hematologist, we are announcing a collaboration with the ASH Image Bank to give you the renamed ASH Image Bank Challenge. Members of that team are now selecting the images and drafting each challenge, which we believe will further elevate the quality of this popular interactive feature. The ASH Image Bank is a web-based library that offers a comprehensive collection of images relating to a wide range of hematologic topics. To access this resource, please visit http://imagebank.hematology.org.
A 25-year-old man with a past medical history of mediastinal germ cell tumor, diagnosed 10 years earlier and treated with surgery and chemotherapy, presented to his primary care physician with chronic fatigue. A complete blood count with differential revealed marked macrocytic anemia (hemoglobin: 4.8 g/dL; mean corpuscular volume: 101 fL), leukopenia (1.4 × 109/L), neutropenia (0.14 × 109/L), mild eosinophilia (12%), and a normal platelet count. He reported taking high doses of zinc to prevent potential infection with the virus that causes COVID-19. Aspiration and a bone marrow biopsy were performed. Cytogenetic studies performed on the bone marrow sample showed no karyotypic abnormalities. A next-generation sequencing myeloid panel revealed no somatic mutations. Flow cytometric immunophenotyping showed no immunophenotypic abnormalities; B cells and plasma cells were polytypic.
What is the diagnosis?
Therapy-related myelodysplastic syndrome
Plasma-cell myeloma
Chronic eosinophilic leukemia
Copper deficiency
For the solution to the quiz, visit The Hematologist online, https://ashpublications.org/thehematologist/pages/a_young_man_with_anemia_and_neutropenia.
Bone marrow aspirate smear. The figure shows erythroid hyperplasia with increased density of left-shifted erythroid precursors, dyserythropoeiesis, and cytoplasmic vacuolization of a subset of erythroid precursors.
Bone marrow aspirate smear. The figure shows erythroid hyperplasia with increased density of left-shifted erythroid precursors, dyserythropoeiesis, and cytoplasmic vacuolization of a subset of erythroid precursors.
Bone marrow core biopsy. The bone marrow is normocellular for the patient’s age and is characterized by a decreased myeloid-erythroid ratio with morphologically unremarkable megakaryocytes.
Bone marrow core biopsy. The bone marrow is normocellular for the patient’s age and is characterized by a decreased myeloid-erythroid ratio with morphologically unremarkable megakaryocytes.
Iron stain performed on the bone marrow aspirate smear. Ring sideroblast counts are increased.
Iron stain performed on the bone marrow aspirate smear. Ring sideroblast counts are increased.
Peripheral blood smear. The figure shows marked anemia and neutropenia with adequate platelets.
Peripheral blood smear. The figure shows marked anemia and neutropenia with adequate platelets.
Competing Interests
Dr. Loghavi indicated no relevant conflicts of interest.